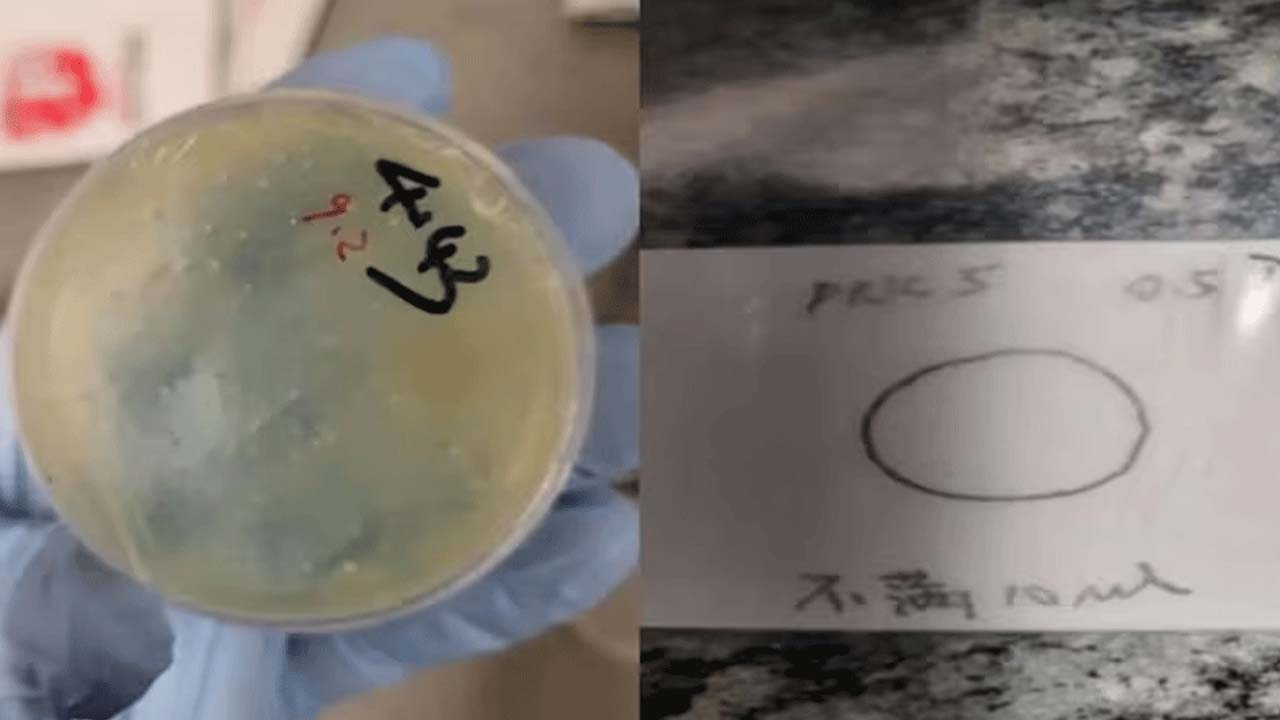
U.S. Arrests Wuhan Researcher for Smuggling Biological Materials Amid Rising Concerns

Washington: Another Chinese researcher has been arrested in the U.S. A Ph.D. student working at the Wuhan lab was caught smuggling biological materials. This marks the second such incident within just a week. The FBI arrested Chengzhan Han in Detroit, who had reportedly mailed four types of biological instruments. FBI Chief Kash Patel stated in a post that the person who received the biological materials lied during questioning. She is the third Chinese researcher recently booked for smuggling. On June 4, a Chinese couple was arrested for allegedly smuggling a dangerous biological pathogen, which had the potential to be used as an agro-terror weapon.
COVID-19 is believed to have originated from Wuhan. The Chinese researcher reportedly sent four parcels to four individuals working at the University of Michigan. Initially, she gave false statements to the police regarding the parcels, but later admitted her offense before the FBI and customs officials. The parcels are suspected to have contained silkworm-like insects. According to the FBI director, she also deleted data from her electronic devices a day before she was questioned.
On June 4, two Chinese nationals were caught smuggling Fusarium graminearum fungus, which has the potential to destroy crops. With two such smuggling cases occurring in just one week, the FBI has raised serious concerns. The U.S. has strongly condemned the stance of the Chinese Communist Party in light of these events.












